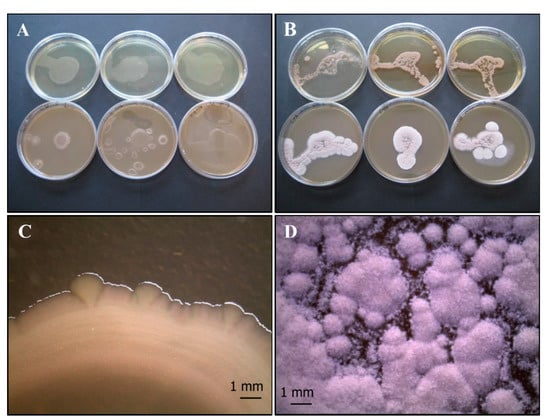
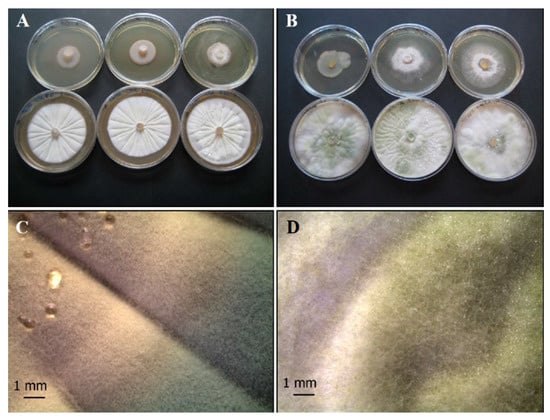
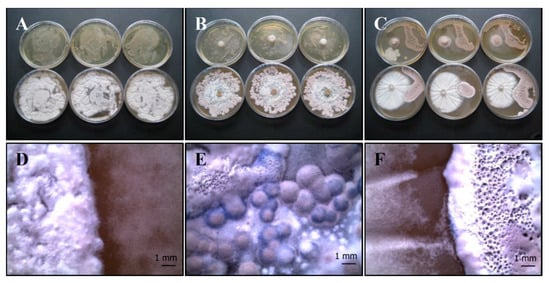

Abstract
Is it possible to improve the efficiency of bioremediation technologies? The use of mixed cultures of bacteria and fungi inoculated at the rhizosphere level could promote the growth of the associated hyperaccumulating plant species and increase the absorption of metals in polluted soils, broadening new horizons on bioremediation purposes. This work investigates interactions between Ni-tolerant plant growth-promoting bacteria and fungi (BF) isolated from the rhizosphere of a hyperaccumulating plant. The aim is to select microbial consortia with synergistic activity to be used in integrated bioremediation protocols. Pseudomonas fluorescens (Pf), Streptomyces vinaceus (Sv) Penicillium ochrochloron (Po), and Trichoderma harzianum group (Th) were tested in mixes (Po-Sv, Po-Pf, Th-Pf, and Th-Sv). These strains were submitted to tests (agar overlay, agar plug, and distance growth co-growth tests), tailored for this aim, on Czapek yeast agar (CYA) and tryptic soy agar (TSA) media and incubated at 26 ± 1 °C for 10 days. BF growth, shape of colonies, area covered on plate, and inhibition capacity were evaluated. Most BF strains still exhibit their typical characters and the colonies separately persisted without inhibition (as Po-Sv) or with reciprocal confinement (as Th-Sv and Th-Pf). Even if apparently inhibited, the Po-Pf mix really merged, thus obtaining morphological traits representing a synergic co-growth, where both strains reached together the maturation phase and developed a sort of mixed biofilm. Indeed, bacterial colonies surround the mature fungal structures adhering to them without any growth inhibition. First data from in vivo experimentation with Po and Pf inocula in pot with metalliferous soils and hyperaccumulator plants showed their beneficial effect on plant growth. However, there is a lack of information regarding the effective co-growth between bacteria and fungi. Indeed, several studies, which directly apply the co-inoculum, do not consider suitable microorganisms consortia. Synergic rhizosphere BFs open new scenarios for plant growth promotion and soil bioremediation.
1. Introduction
Bacteria and fungi are simultaneously present in a wide variety of environments [1]. These organisms are capable not only of coexisting, but also of actively interacting and the bacteria-fungal interactions (BFIs) range from antagonism to mutualism [2,3]. BFIs in many cases form physically and metabolically interdependent consortia with peculiar characteristics different from those of their individual components [3].
Bacteria and fungi affect their microenvironment by producing secretes and metabolites to compete with each and/or other organisms [2,3]. However, they can also live in synergistic communities, cooperating to survive and thrive together [1,4,5,6].
BFIs play a key role in most of natural ecosystems, driving biogeochemical cycles, contributing to both the health and diseases of plants and animals [2], as well as degrading and inactivating pollutants [7].
Beneficial effects of soil biotic components are often applied in the eco-friendly bioremediation techniques that use living organisms (i.e., bacteria, fungi, and plants) to remove or neutralize hazardous organic and/or inorganic compounds in polluted sites [8,9,10]. These technologies can exploit native organisms to detoxify and remove pollutants from soil, through their different metabolic capabilities: enzymes, organic acids, and secondary metabolites [11,12]. Recently, many studies highlighted the beneficial effects of inoculating microbial consortia at the root level to reduce toxic effects and concentration of persistent organic and inorganic contaminants (e.g., metals) [13,14,15,16,17,18].
Rhizospheric plant growth-promoting bacteria (PGPB) and plant growth promoting fungi (PGPF) are used because of their interactions with roots (e.g., increasing solubility of nutrient trace elements, root surface area and root hair development, accumulation of metals) of different plants species [19,20,21,22,23,24].
Soil microorganisms may biotransform metals into less toxic forms uptaken by plants and they are also able to release plant growth regulators [25], such as 1-aminocyclopropane-1-carboxylic Acid (ACC) deaminase, indole-3-acetic acid (IAA), synthesize siderophores and solubilize and mineralize phosphate [26,27,28,29].
It is known that plant-associated microbiota play an important role in plant trace elements bioaccumulation [30,31]. BFIs, in fact, are part of a communication network that keeps microhabitats in balance [32]. The synergic activity of certain fungi and bacteria has been already documented, demonstrating the improved ability of BFIs in remediation of hydrocarbons and crude oil [33,34,35,36].
Despite the great potential of plant growth-promoting (PGP) microorganisms, little is still known about their mutual behavior and possible positive interactions between fungi and PGP bacteria. To date, studies have focused mainly on the evaluation of the antagonistic properties of bacterial isolates against fungal isolates whilst possible synergic effect of bacteria-fungi interactions has generally been neglected [37,38].
Recently, we isolated and characterized bacterial and fungal strains in metalliferous soils [24] from the rhizosphere of Alyssoides utriculata (L.) Medik., a nickel hyperaccumulator plant [39]. Among the isolated strains, we selected the most performing culturable bacteria and fungi in terms of Ni tolerance and PGP traits: Pseudomonas fluorescens Migula, 1895 complex, Streptomyces vinaceus Jones, 1952, Penicillium ochrochloron Biourge 1923, and Trichoderma harzianum Rifai 1969 group strains that were the most promising for integrated nickel bioremediation [24,40,41,42].
This work investigates the possible mutual interactions between the above mentioned bacterial (P. fluorescences, S. vinaceus) and fungal strains (P. ochrochloron and T. harzianum group) in vitro and assesses in vivo effect in Ni-hyperaccumulator plants on metalliferous soils with the aim of selecting synergic microbial consortia employable for integrated plant-fungi-bacteria bioremediation purposes.
2. Materials and Methods
2.1. Organisms Selection and In Vitro Co-Growth Tests
The used strains were deposited in the microbial Collection of DISTAV of the University of Genoa, associated member of the Microbial Resource Research Infrastructure Italian Node (CoLD-MIRRI-IT-UNIGE), and were previously isolated and characterized for the high Ni tolerance and the PGP traits [24]. The high Ni tolerance of Pseudomonas fluorescens SERP1 complex, Streptomyces vinaceus SERP4, Penicillium ochrochloron Serp03S, and Trichoderma harzianum group Serp05S was evaluated on Tryptic Soy Agar (TSA, Sigma-Aldrich, St. Louis, MO, USA) spiked with Ni up to 20 mM [24]. Thanks to these traits, strains were used in the following co-growth tests.
Bacterial strains were grown in cell culture flasks containing tryptic soy broth (TSB, Sigma Aldrich) until reaching the exponential growth phase. The first strain was incubated overnight at 26 ± 1 °C, while the second was kept at 26 ± 1 °C for 72 h, then revived 1:20 in the same growth medium and finally incubated for 30 h. Bacterial cells pellets were washed twice in 1× phosphate-buffered saline (PBS) solution pH 7.4 and then concentrated [43] to obtain the final concentration of 108 Colonies Forming Units (CFUs) mL−1 measured spectrophotometrically.
Fungal strains of P. ochrochloron and T. harzianum group were plated on malt extract agar (MEA) and kept at 24 ± 1 °C until conidiogenesis. In addition to the pure fungal culture on MEA agar, an aliquot of well-grown fungal colony was diluted in distilled sterile water and estimated by cell counts using a Bürker chamber up to a liquid culture concentration of 108 CFUs mL−1.
For each bacterium and each fungus previously selected, in addition to the controls, three methods of inoculum were adopted onto two different substrates Czapek Yeast extract Agar (CYA) and TSA at pH 6, and each method was carried out in triplicate (N = 30 each mixed culture test): (a) agar overlay method (100 µL of fungal liquid culture were spread on solid medium and 100 μL of bacterial suspension were inoculated at the center of the Petri dishes); (b) agar plug method (Ø 5 mm agar disc from well-grown lawn of the fungus was cut and transferred on agar plate previously stroked with 100 μL of the bacterial suspension); (c) distance growth method (Ø 5 mm fungal agar plug and 100 µL of the bacterial suspension were inoculated 3 cm away from each other on the same plate). Agar plates (90 mm Ø) with a single central culture of the selected bacteria and fungi were used as positive control.
P. fluorescens SERP1 complex and S. vinaceus SERP4 were grown in cell culture flasks containing tryptic soy broth (TSB, Sigma-Aldrich) as previously described to reach the exponential growth phase.
P. ochrochloron Serp03S and T. harzianum Serp05S group were plated on MEA agar and kept at 24 ± 1 °C until conidiogenesis. The different bacterium-fungus mixes and the positive controls were then incubated at 26 ± 1 °C and the growth of the isolates was daily monitored for 10 days.
Mycelial and bacterial growth was assessed by measuring colony area and the percentage inhibition (Pi%) [44], calculated according to the formula:
where Pi% = percentage inhibition ratio, C = average control area (mm2) of the colony and T = average treatment area (mm2) of the colony.
2.2. Stereomicroscopy and Optical Microscopy
The Petri dishes were observed under a stereomicroscope and the images were processed with the Leitz(sche) Camera (LEICA, Wetzlar, Germany) application suite (LAS EZ) software to monitor the co-growth of the microbiota after 10 days of incubation and the corresponding shape of both colonies. Subsequently, the in-depth observation of microfungal structures of culturable mix was appreciated through an optical microscope magnified at 40× and 63× and the resulting images were processed using the LEICA IM50 software, while the Gram staining allowed us to underline the Gram+ and Gram- bacteria.
2.3. Scanning Electron Microscopy
In order to carefully observe the best grown mixed culture of microbiota after 14 days-incubation on CYA, the isolates mix were fixed in phosphate 10% buffered formalin and dehydrated in ethanol series [45]. The samples were then mounted on SEM stubs, sputter-coated with gold and viewed with a VEGA3 SEM (TESCAN, Libušina, Czech Republic) at HV20.0 kV, using backscattered electrons (BSE).
2.4. Soil Sampling and Processing for In Vivo Experimentation
Serpentine soil was collected from Sassello (SV, Italy N 44°48′63″; E 8°51′87″) at 0–30 cm (A horizon) and 30–60 cm (C horizon) depth, mixed to obtain a homogeneous sample, air de-hydrated and sieved through a sequential 4 mm and 2 mm mesh. One soil fraction was used as is for Control, the other fractions were oven dried at 130° for 24 h to sterilize the growing substrate, then mixed 1:1 (v/v) to obtain the testing substrates for pot experiment. Soil chemical composition is reported [46], as shown following in Table 1.

Table 1.
Chemical composition of the studied soils (Avg = average; M = median; Min = minimum; Max = maximum). Major and minor elements are reported as oxide wt %; selected PTEs are reported in mg/kg [46].
2.5. Plant Preparation for In Vivo Experimentation
Seeds of Ni-hyperaccumulator Alyssoides utriculata (n = 200) were collected from a serpentine area in NW Italy (Voltri Massif N 44°28′49″, E 8°40′44″) and grown in greenhouse on sterilized serpentine soil (Section 2.4) for 6 months.
2.6. In Vivo Experimental Design
Four L of substrate prepared as previously described (approx. 4.5 kg each pot) was divided into Control, Bacteria (BI, inoculum with Pseudomonas fluorescens), Fungi (FI inoculum with Penicillium ochrocloron) and Mix (MIX co-inoculum Po + Pf), 30 replicates each series. Soils were hydrated at 70% water holding capacity and subsequently irrigated once a week to keep them at optimum hydration level. After three months from the inocula, pots series were completely randomized, and six-months old plants were then transplanted in the pots. All the pots had their saucers to recover the irrigation water.
2.7. Bacteria and Fungi Co-Inoculum in In Vivo Experimentation
The selected P. ochrochloron strain (FI) was isolated as pure colony on MEA (Sigma-Aldrich) and incubated in the dark at 24 ± 1 °C for at least one week. Once the pure colony has been grown and the conidiogenesis was reached, mycelium and conidia were collected with sterile loop and resuspended in 100 mL of sterile distilled water up to a final concentration of about 108 CFUs mL−1. To verify the final fungal concentration, aliquots of this latter solution were transferred to the Bürker chamber for conidia count.
P. fluorescens strain (BI) was repeatedly isolated to obtain a pure colony on TSA (Sigma-Aldrich) incubated at 26 ± 1 °C in the dark for at least 24–48 h. One day before the experiment, a well isolated colony is transferred to a cell culture flask containing 200 mL of TSB (Sigma-Aldrich) and incubated overnight at 26 ± 1 °C. The subsequent day, the cultural broth is transferred into 50 mL falcon tubes which are centrifuged at 4500× g for 10 min at 20 °C. Then, the supernatant is gently removed from each falcon tube and the pellet is subjected to washing with an equal volume of PBS (pH 7.4). A spectrophotometer analysis allows to determine the optical density (OD) at a wavelength of 600 nm. Finally, the pellet obtained after a second centrifugation is resuspended in 100 mL of physiological saline solution. After an overnight incubation of P. fluorescens at 26 ± 1 °C the obtained OD is 0.5, which corresponds to an average concentration of 2.5 × 108 CFUs mL−1 of the Gram-negative bacterium P. fluorescens. Furthermore, the bacterial suspension is concentrated twice, to obtain a final concentration of 5 × 108 CFUs mL−1.
The BI and FI inoculation in pots is carried out immediately after their preparation, transferring 1 mL of bacterial and fungal suspension of about 108 CFUs mL−1 on the soils in the pot centre.
2.8. Microbiota Assessment
The fungal and bacterial diversity and abundance were monitored at month I (without plants) and XII (with six-months old plants) after the inocula. Soil was sampled in each pot and mixed for each treatment to obtain a composite sample. Soils samples were collected for every type of treatment: fungal inoculum (FI), bacteria inoculum (BI), fungal-bacteria co-inoculum (MIX), native soil without inocula (Control). Microorganisms were extracted from 3 g of soil by using 30 mL of sterile saline solution (NaCl 0.9% w/v). Aliquots were serially diluted (1:10) up to 10−5 and 100 µL of each dilution was spread on Rose Bengal Agar (RBA) and MEA. Petri dishes (Ø 90 mm) for fungi and TSA (Sigma-Aldrich) for bacteria were employed. Then, fungal plates (N = 24) were incubated in the dark at 24 ± 1 °C and monitored every day for a week, while bacterial plates (N = 16) were incubated in the dark at 26 ± 1 °C for 72–96 h. The fungal and bacterial colonies were counted as Colonies Forming Units per g of dry soil (CFUs g−1) for each morphotype grown and repeatedly isolated on agar plates to obtain a pure colony.
2.9. Data Analysis
For each treatment, the images of the bacterial and fungal colonies were processed with ImageJ software [47,48] to estimate the surface area. Data are presented as mean ± Standard Deviation. The percentage of the inhibition rate was obtained considering the average surface of the bacterial and fungal colonies.
3. Results
3.1. In Vitro Tests
The screening tests of co-growth showed that CYA and TSA buffered at pH 6.0 resulted the most suitable agar substrates for the growth of both bacterial and fungal strains.
Fungal strains exhibited an increased growth on the CYA substrate compared to TSA pH 6.0, whereas bacteria thrive on both agar culture media.
P. fluorescens (Pf) forms small, low convex, colorless colonies, although white-cream pigmentation is frequent [49] (Figure 1A,C), while S. vinaceus (Sv) forms slow-growing, circular, convex, and rough colonies (Figure 1B,D). This latter bacterium is characterized by a macroscopic mycelium morphology including pellets and clump formation [50].
Figure 1.
Growth of control bacterial strains P. fluorescens complex SERP1 (A,C) and S. vinaceus SERP4 (B,D) on TSA (upper row of plates, A and B, respectively) and on CYA (lower row of plates, A and B, respectively). Stereo Microscope details of single colony shape of P. fluorescens (C) that forms small, low convex, colorless or white-cream colonies, and S. vinaceus (D) that forms circular, convex, and rough colonies with a macroscopic mycelium morphology including pellets and clump formation. N = 30 each test.
As concerns fungi, the colony of P. ochrochloron (Po) on CYA appears round, grooved in a radial pattern, white to light grey in the margin once maturation is reached (Figure 2A,C). This fungus exhibits fast growth rate, and its colonies are variously branched, with asymmetrically and/or symmetrically branched conidiophores [51].
Figure 2.
Growth of control fungal strains P. ochrochloron Serp03S (A,C) and T. harzianum group Serp05S (B,D) on TSA (upper row of plates, A and B, respectively) and on CYA (lower row of plates, A and B, respectively). Stereo Microscope details of single colony shape of P. ochrochloron (C) that appears round, grooved in a radial pattern, white to light grey in the margin once maturation is reached and T. harzianum (D) that produces typical rough and globose to subglobose yellow or green conidia. N = 30 each test.
T. harzianum group (Th) isolates (Figure 2B,D) produce typical rough and globose to subglobose conidia and their color was yellow or green [52,53,54]; conidia production is greater in the middle of the plate with respect to the margins.
The results of co-growth tests are summarized as follows:
(a) P. ochrochloron (Serp03S) vs. P. fluorescens (SERP1): Po-Pf mix
The agar overlay method (Figure 3A,D) on CYA does not seem to clarify any relationship between the two organisms. The bacterium develops where it has been inoculated, while the fungus grows better around bacterium. After 10 days of incubation the fungus reaches maturation, taking on a grey-black color.

Figure 3.
Growth of P. ochrochloron Serp03S and P. fluorescens complex SERP1 (Po-Pf mix) in co-growth tests on TSA (upper row of plates, A–C, respectively) and on CYA (lower row of plates, A–C, respectively). Method of inoculum: (A) agar overlay. (B) agar plug, (C) distance growth. Stereo Microscope details of colony shape when grown in mix (D–F). In the agar overlay method, Po grows around Pf reaching maturation and its color turns to grey-black (D). In the agar plug method (E) and in the distance growth method (F) the contact between the two organisms develops a peculiar round structure with concentric rings. N = 30 each test.
Interestingly, in the agar plug (Figure 3B,E) and in the distance growth methods (Figure 3C,F) the contact between the two organisms develops a peculiar round structure with concentric rings that represents a sort of synergic growth.
(b) P. ochrochloron (Serp03S) vs. S. vinaceus (SERP4): Po-Sv mix
The mixed culture covers almost the entire agar plate, taking on a grey-white color both in the overlay (Figure 4A,D) and plug test (Figure 4B,E). No zones of inhibition are visible in the distance growth method, specifically in the contact zone (Figure 4C,F), but each strain maintained a distinct colony shape in terms of macroscopic characteristics.
Figure 4.
Growth of P. ochrochloron Serp03S and S. vinaceus complex SERP4 (Po-Sv mix) in co-growth tests on TSA (upper row of plates, A–C, respectively) and on CYA (lower row of plates, A–C, respectively). Method of inoculum: (A) agar overlay, (B) agar plug, (C) distance growth. Stereo Microscope details of colony shape when grown in mix (D–F). In the agar overlay and, in the agar plug method the mixed culture turns on grey-white color (A,B). In the distance growth method (F) no zones of inhibition are visible, specifically in the contact zone, but each strain maintained a distinct colony shape in terms of macroscopic characteristics. N = 30 each test.
(c) T. harzianum group (Serp05S) vs. P. fluorescens complex (SERP1): Th-Pf mix
In the agar overlay method the fungus does not thrive where the bacterium was inoculated (Figure 5A,D). Conversely in the other treatments (agar plug, Figure 5B,E and distance growth, Figure 5C,F) the fungus covers almost the entire agar plate, but its growth appears to be disturbed: in the last distance growth method, fungal strain is confined in its half of the plate.

Figure 5.
Growth of T. harzianum Serp05S and P. fluorescens complex SERP1 (Th-Pf mix) in co-growth tests on TSA (upper row of plates, A–C, respectively) and on CYA (lower row of plates, A–C, respectively). Method of inoculum: (A) agar overlay, (B) agar plug, (C) distance growth. Stereo Microscope details of colony shape when grown in mix (D–F). In the agar overlay method the fungus does not thrive where the bacterium was inoculated (D). In the distance growth method, Th growth is disturbed and confined in its half of the plate (C,F). N = 30 each test.
(d) T. harzianum (Serp05S) vs. S. vinaceus (SERP4): Th-Sv mix
The bacterial colonies appear smaller than the control and the fungus reaches maturation later than pure colonies. The bacterium grows only in the center of the plate in the overlay agar test (Figure 6A,D), while the fungus appears to be inhibited in the agar plug test (Figure 6B,E). Bacteria and fungi tolerate each other, as shown by the contact between the two microorganisms (Figure 6C,F), but they remain distinct.

Figure 6.
Growth of T. harzianum Serp05S and S. vinaceus complex SERP4 (Th-Sv mix) in co-growth tests on TSA (upper row of plates, A–C, respectively) and on CYA (lower row of plates, A–C, respectively). Method of inoculum: (A) agar overlay, (B) agar plug, (C) distance growth. Stereo Microscope details of colony shape when grown in mix (D–F). In the agar overlay method, Sv only grows in the center of the plate (D). In the agar plug method, Th appears to be inhibited (E). In the distance growth method, Th and Sv tolerates each other without reciprocal inhibition in the contact zone but persists distinct (F). N = 30 each test.
3.1.1. Stereomicroscopy and Optical Microscopy
In-depth observation of the best co-grown bacterium and fungus mix (Po-Pf mix) under the optical microscope (Figure 7A,B) shows the typical fungal conidiophore branching patterns mostly symmetrical and mono- and biverticillated [55]. The Gram staining underlines the Gram-negative bacterium P. fluorescens complex, counter-stained pink by safranin (Figure 7C,D). However, the conidiophores of P. ochrochloron are also clearly stained with a bright red color.

Figure 7.
Optical Microscope images (40×) of (A) mono- and biverticillate branched conidiophores of P. ochrochloron Serp03S in the co-growth method and (B) maturation of conidia on conidiophores, in detail. Gram staining images of P. ochrochloron Serp03S and P. fluorescens SERP1 by Optical Microscope at 63× magnification. In detail (C) the mass of fungal hyphae and (D) the branched conidiophores of P. ochrochloron surrounded by bacterial cells that do not retain the crystal violet stain used in the Gram-staining method (pink-red rods).
3.1.2. Scanning Electron Microscopy
The backscattered (BSE) SEM imaging of the best co-grown bacterium and fungus mix (Po-Pf mix) highlights clusters of fungal hyphae enveloped by groups of flagellate Pf (Figure 8A,B). Conidiophores are often covered on the tip by bacterial colonies adhering by means of adhesive filaments that provide a compact structure to bacterial biofilm consisting of live and dead cells (Figure 8C,D). Fungal spherical conidia are still borne (Figure 8E) or free (Figure 8F) on specialized stalks of the conidiophore that is characterized by typical vial-shaped cell (i.e., phialide), as shown in Figure 8D.

Figure 8.
Backscattered electron (BSE) SEM images of the mixed culture of P. ochrochloron Serp03S and P. fluorescens SERP1: (A) tangle of fungal hyphae covered by bacteria. Magnification 1.90 kx, Working Distance 10.51 mm; (B) growing hyphal tip surrounded by cluster of bacteria jointed by means of adhesins. Magnification 19.8 kx, Working Distance10.84 mm; (C) large group of branching biverticillated conidiophores. Magnification 4.63 kx, Working Distance 10.66 mm; (D) detail of branch (1) metula (2) interfaces with bacteria adherent to phialides (3). Magnification 10.6 kx, Working Distance 10.51 mm; (E) mature conidia on conidiophores. Magnification 20.0 kw, Working Distance 10.57 mm; (F) fungal conidia (2 µm diameter) and bacterial colonies (1 µm length), some of which in death phase; the rough surface of the conidia seems to encourage the adhesion of the bacteria cells.
3.1.3. Mutual Growth Inhibition
The analysis of bacterial and fungal growth reveals that the measured area is a very critical parameter to evaluate the inhibition of the colonies’ growth (Table 2).

Table 2.
Estimation of the surface area of bacterial and fungal colonies in control plates and in different distance growth treatments. Data are mean ± SD. N = 3 each colony. Po: P. ochrochloron; Th: T. harzianum; Pf: P. fluorescens; Sv: S. vinaceus.
Fungi grow slower than bacteria, but the expansion over time of mycelium is greater than that of bacterial colonies. Therefore, fungal strains show a greater surface coverage than the bacterial one. T. harzianum group covers the entire round surface area of the agar plate (90 mm Ø) and P. ochrochloron occupies about 70% of the surface area of the circle.
Conversely, the bacterial strains show a limited growth close to the initial bacterial suspension (~25% of the plate surface). As shown in Table 3, P. fluorescens shows a marked reduction in colony area in the co-growth treatment with both P. ochrochloron (>50% for the average area) and T. harzianum group (>70% for the average area).

Table 3.
Mutual inhibition of bacterial and fungal growth at different distance growth treatments. N = 3 each colony. Po: P. ochrochloron; Th: T. harzianum; Pf: P. fluorescens; Sv: S. vinaceus.
However, this result is difficult to explain in the distance growth test with P. ochrochloron: the development of a sort of synergic growth between these two microorganisms does not allow to distinguish the distinct shape of the two colonies that completely merged. This phenomenon was also observed by optical and scanning electron microscopy. On the contrary, S. vinaceus is less sensitive to co-growth with other fungal strains, showing a low percentage of inhibition. This is especially true for the test between S. vinaceus and P. ochrochloron (~8% inhibition). The fungus instead shows a surface area variation roughly ranging from 30 to 40%. Similar findings for all the treatments including T. harzianum group, which shows signs of suffering with respect to the control.
3.2. In Vivo Experimentation
3.2.1. Assessment of Culturable Fungi
One month from the inoculation five different fungal morphotypes were recognized in the plated soils. The fungal abundance was very high in the control and in the BI samples. The main representative fungus morphotype was Penicillium cfr. ochrochloron. Other fungi were Trichoderma strain, isolated in each soil sample except the control; Neurospora sp., isolated in each sample except the FI and MIX; Mucor sp. isolated in each sample, and Aspergillus sp. isolated in control and BI samples. The abundance of each morphotype is reported in Figure 9.

Figure 9.
Average fungal count expressed as genus diversity and colony forming units (CFUs g−1) in the rhizospheric soil one-month post inoculation: control, fungal inoculum; bacterial inoculum; MIX treatment. N = 16 each treatment.
Twelve months after the inoculation, three different fungal morphotypes were identified in the plates. The fungal abundance was homogenized in the samples, but the Penicillium cfr. ochrochloron was the most represented species, followed by Mucor sp. and Trichoderma sp. No Aspergillus sp. and Neurospora sp. strains were isolated from the plates. The abundance of each morphotype is reported in Figure 10.

Figure 10.
Average fungal count expressed as genus diversity and colony forming units (CFUs g−1) in the rhizospheric soil twelve-months post inoculation: control, fungal inoculum; bacterial inoculum; MIX treatment. N = 16 each treatment.
3.2.2. Assessment of Culturable Bacteria
One month after inoculation a greater diversity is observed, where P. fluorescens has been added to the soil (BI and MIX) compared to control and FI treatments (Figure 11). In general, there is a prevalence of genus Pseudomonas sp. which represents more than 75% of total culturable bacterial strains in BI, while it stands around 34% in the MIX.

Figure 11.
Average bacterial count expressed as genus diversity and colony forming units (CFUs g−1) in the rhizospheric soil one-month post inoculation: control, fungal inoculum; bacterial inoculum; MIX treatment. N = 16 each treatment.
It is interesting to note that the dominant bacterial strain in FI (~85%) is Erwinia sp., while the Pseudomonadaceae are dominant in control (97.5%).
After twelve months, although there are no significant differences on the isolated morphotypes, Pseudomonas sp. it is no longer the most abundant genus in BI (−22%). In fact, Streptomyces sp. (−24%) and Erwinia sp. thrive in all types of treated soils. In fact, the pie chart in Figure 12 shows that Erwinia sp. represents half of the bacterial colonies isolated in BI, 66% and 68% in FI and MIX respectively and even represents the monospecific community in control.

Figure 12.
Average bacterial count expressed as genus diversity and colony forming units (CFUs g−1) in the rhizospheric soil twelve-months post inoculation: control, fungal inoculum; bacterial inoculum; MIX treatment. N = 16 each treatment.
3.2.3. Plant Growing
Six months after transplanting, plants from inoculated or co-inoculated pots are markedly different respect to control. These latter showed reduced growth with absence of secondary branches and were about 10 times smaller than inoculated plants (Figure 13).

Figure 13.
Plants of Alyssoides utriculata six months after transplanting in control soil, and in soil inoculated with bacteria (BI), fungi (FI) and MIX (Pf + Po).
The overall growth was MIX > BI > FI > CONTROL.
4. Discussion
The co-growth tests between bacterial and fungal strains allow establishing the positive or negative interactions and the mutual behavior of the selected strains. Most of the bacterial and fungal strains used in mixes showed typical macro- and micromorphology where the two strains separately persisted without inhibition (as in Po-Sv), or with reciprocal confinement sometimes developing slower than expected (as in Th-Sv and Th-Pf). On the contrary, this study highlighted for the first time the morphological traits that represent a sort of synergic co-growth, as in the Po-Pf mix, where both strains really merged and developed some new features that can be assumed as a mixed biofilm, while reaching the maturation phase (Figure 7C,D and Figure 8). However, further investigations are needed to assure that the reduction of surface area in both strains is only related with the merged shape that do not allow to distinguish the distinct morphology of the two colonies. Specifically, the Pseudomonas strain belonging to the fluorescens complex is considered the most promising group of PGPR involved in the biocontrol of plant diseases for its antifungal metabolites production [42], despite this trait is almost absent in the SERP1 strain used for the present co-growth test. In addition, certain P. fluorescens strains can detoxify organic and inorganic pollutants, combating heavy metal pollution and bioremediating pesticides [56,57]. Regarding Penicillium ochrochloron here studied, the Ni tolerance and the metal uptake ability were already documented [24,40]. Moreover, P. ochrochloron is a metal-resistant fungus [58], highly tolerant to copper and other metals [59].
Although the analysis of bacteria and fungi allowed defining their individual properties, and potential implications and applications in bioremediation as previously described, the development of integrated protocols, jointly exploiting fungi and bacteria, requires and adequate knowledge of their mutual behavior in the microbial consortium. To date, few works investigated the possible BFIs and synergy between rhizosphere PGP bacteria and microfungi [60,61].
The monitoring of the fungal and bacterial abundance in the in vivo experimentation evidenced how the soils went through an intermediate stage before stabilization. After one month, in fact, the presence of typical environmental fungal strains such as Neurospora sp., Mucor sp., Trichoderma sp. and Aspergillus sp. was reported, and it was particularly high in the Control tests where no fungi were inoculated. Similarly, we can affirm that bacterial diversity traced that observed in other serpentinitic soils [24]. The high abundance of the genus Pseudomonas sp. is affected by the inoculum of 108 CFU mL−1.
However, twelve months after inoculation (and six months after transplanting) data on fungi were more homogeneous. Fungi, in fact, were equally distributed in each test group, Penicillium cfr. ochrochloron was the most abundant strain in each treatment and some morphotypes disappeared (Aspergillus sp. and Neurospora sp.). This is probably due to the fungal strains’ competition, which favored the inoculated strain over time, allowing its aerial dispersion and colonization of sterile near soils of control tests.
On the contrary, the bacterial community showed a greater dominance of a few genera: Erwinia sp. in all treatments (deriving from original soil microbial strains), Pseudomonas sp. (BI and MIX), and Bacillus sp. (FI and MIX). In this case, the competition between microorganisms seemed to favor a ubiquitous strain such as Erwinia sp. isolated on both serpentinite and non-serpentinite sites, in rhizospheric and adjacent bare soil [24]. Previously, PGP and Ni tolerance tests performed on bacterial strains isolated from serpentinite soil [24] belonging to Erwinia sp. showed significant PGPR traits (production of siderophores and solubilization of phosphates). Erwinia tolerated up to 5 mM of Ni compared to Pseudomonas sp. and Streptomyces sp. (up to 15 mM), although it was more competitive from an ecological point of view.
Plants seemed to have a good response to bacterial and fungal inoculum after six months from transplanting in pots. However, in controls tests, where Erwinia genus is dominant, plant growth appeared modest compared to the other treatments. This might be related with the low ability of this microbial strain to alleviate root stress linked to high metal concentrations. Further investigations are required to clarify the interaction between Erwinia and roots and among other fungal strains in co-growth to clarify its possible synergistic traits. Potential Erwinia ‘rhizosphere effect’, described for other microbial strains where root system could promote the bacterial and fungal proliferation [62,63,64,65,66] should be investigated.
5. Conclusions
In conclusion, we identified the PGP strains of P. ochrochloron and P. fluorescens isolated from the rhizosphere of A. utriculata as able to synergically co-grow in a mixed culture developing a biofilm where the two microorganisms merge, reaching the mature stage. Hence, these strains have been employed in the in vivo experimentation on metalliferous soil to directly evaluate their potential synergic role in the rhizosphere of A. utriculata for phytoremediation purposes. Inocula of MIX and Penicillium ochrochloron show the positive effect.
This synergistic fungi-bacteria co-growth opens new perspectives in plants’ growth promotion and soil bioremediation at the rhizosphere level. The achieved results suggest the possible use of mixed inocula to improve the metal uptake of the associated hyperaccumulator plant species in metal-contaminated soils. Moreover, our study evaluated and underlined the relevance and effectiveness of the agar overlay, the agar plugs, and the distance co-growth screening tests for selecting microorganism consortia for biotechnological purposes.
Author Contributions
M.Z. devised the experimental design and S.R. and G.C. conducted related experiments and collected main results. L.V. and A.D.C. performed the microbial genome sequencing and interpreted the microbial data. S.D.P. performed the fungal genome sequencing and interpreted the fungal strain data. M.Z. and E.R. did the data analysis. S.R., G.C., E.R., M.Z. drafted the manuscript. M.G.M., M.Z., L.V. revised and supervised the article. All authors have read and agreed to the published version of the manuscript.
Funding
This research was performed in the frame of the SR’s funded PhD in Biology applied to Agriculture and Environment, (DISTAV-Department of Earth, Environmental and Life Sciences University of Genoa, Italy), XXXI cycle.
Institutional Review Board Statement
Not applicable.
Informed Consent Statement
Not applicable.
Data Availability Statement
Not applicable.
Acknowledgments
Authors wish to thank C. Grande, G. Tassistro and A. Borello, Laboratory of Microbiology and S. Romeo, C. Capelli, Laboratory of Plant Biology, DISTAV-University of Genoa, for their technical support.
Conflicts of Interest
The authors declare that the research was conducted in the absence of any commercial or financial relationships that could be construed as a potential conflict of interest. The funders had no role in the design of the study; in the collection, analyses, or interpretation of data; in the writing of the manuscript, or in the decision to publish the results.
References
- Arvanitis, M.; Mylonakis, E. Fungal–Bacterial Interactions and Their Relevance in Health. Cell. Microbiol. 2015, 17, 1442–1446. [Google Scholar] [CrossRef] [PubMed]
- Deveau, A.; Bonito, G.; Uehling, J.; Paoletti, M.; Becker, M.; Bindschedler, S.; Hacquard, S.; Hervé, V.; Labbé, J.; Lastovetsky, O.A. Bacterial–Fungal Interactions: Ecology, Mechanisms and Challenges. FEMS Microbiol. Rev. 2018, 42, 335–352. [Google Scholar] [CrossRef] [PubMed]
- Frey-Klett, P.; Burlinson, P.; Deveau, A.; Barret, M.; Tarkka, M.; Sarniguet, A. Bacterial-Fungal Interactions: Hyphens between Agricultural, Clinical, Environmental, and Food Microbiologists. Microbiol. Mol. Biol. Rev. 2011, 75, 583–609. [Google Scholar] [CrossRef]
- Mee, M.T.; Wang, H.H. Engineering Ecosystems and Synthetic Ecologies. Mol. Biosyst. 2012, 8, 2470–2483. [Google Scholar] [CrossRef] [PubMed]
- Partida-Martinez, L.P.; Monajembashi, S.; Greulich, K.-O.; Hertweck, C. Endosymbiont-Dependent Host Reproduction Maintains Bacterial-Fungal Mutualism. Curr. Biol. 2007, 17, 773–777. [Google Scholar] [CrossRef] [PubMed]
- Scherlach, K.; Graupner, K.; Hertweck, C. Molecular Bacteria-Fungi Interactions: Effects on Environment, Food, and Medicine. Annu. Rev. Microbiol. 2013, 67, 375–397. [Google Scholar] [CrossRef] [PubMed]
- Gouma, S.; Fragoeiro, S.; Bastos, A.C.; Magan, N. 13-Bacterial and Fungal Bioremediation Strategies. In Microbial Biodegradation and Bioremediation; Das, S., Ed.; Elsevier: Oxford, UK, 2014; pp. 301–323. ISBN 978-0-12-800021-2. [Google Scholar]
- Cecchi, G.; Vagge, G.; Cutroneo, L.; Greco, G.; Di Piazza, S.; Faga, M.; Zotti, M.; Capello, M. Fungi as Potential Tool for Polluted Port Sediment Remediation. Environ. Sci. Pollut. Res. 2019, 1–8. [Google Scholar] [CrossRef] [PubMed]
- Chawla, N.; Sunita, S.; Kamlesh, K.; Kumar, R. Bioremediation: An Emerging Technology for Remediation of Pesticides. Res. J. Chem. Environ. 2013, 17, 88–105. [Google Scholar]
- González-Martínez, A.; de Simón-Martín, M.; López, R.; Táboas-Fernández, R.; Bernardo-Sánchez, A. Remediation of Potential Toxic Elements from Wastes and Soils: Analysis and Energy Prospects. Sustainability 2019, 11, 3307. [Google Scholar] [CrossRef]
- Kumar, V.; SHahi, S.; Singh, S. Bioremediation: An Eco-sustainable Approach for Restoration of Contaminated Sites. In Microbial Bioprospecting for Sustainable Development; Springer: Singapore, 2018; pp. 115–136. ISBN 9789811300530. [Google Scholar]
- Pandey, A.; Tripathi, P.; Pandey, S. Removal of Toxic Pollutants From Soil Using Microbial Biotechnology. In Microbial Biotechnology in Environmental Monitoring and Cleanup; IGI Global: Hershey, PA, USA, 2019; p. 20. [Google Scholar]
- Ali, H.; Khan, E.; Sajad, M.A. Phytoremediation of Heavy Metals—Concepts and Applications. Chemosphere 2013, 91, 869–881. [Google Scholar] [CrossRef]
- van der Ent, A.; Baker, A.J.M.; Reeves, R.D.; Pollard, A.J.; Schat, H. Hyperaccumulators of Metal and Metalloid Trace Elements: Facts and Fiction. Plant Soil 2013, 362, 319–334. [Google Scholar] [CrossRef]
- Greipsson, S. Phytoremediation. Nat. Educ. Knowl. 2011, 3, 7. [Google Scholar]
- Guarino, C.; Spada, V.; Sciarrillo, R. Assessment of Three Approaches of Bioremediation (Natural Attenuation, Landfarming and Bioagumentation–Assistited Landfarming) for a Petroleum Hydrocarbons Contaminated Soil. Chemosphere 2017, 170, 10–16. [Google Scholar] [CrossRef]
- Paliwal, V.; Puranik, S.; Purohit, H.J. Integrated Perspective for Effective Bioremediation. Appl. Biochem. Biotechnol. 2012, 166, 903–924. [Google Scholar] [CrossRef]
- Sun, J.; Pan, L.; Tsang, D.C.; Zhan, Y.; Zhu, L.; Li, X. Organic Contamination and Remediation in the Agricultural Soils of China: A Critical Review. Sci. Total Environ. 2018, 615, 724–740. [Google Scholar] [CrossRef] [PubMed]
- Alford, É.R.; Pilon-Smits, E.A.H.; Paschke, M.W. Metallophytes—A View from the Rhizosphere. Plant Soil 2010, 337, 33–50. [Google Scholar] [CrossRef]
- Beneduzi, A.; Ambrosini, A.; Passaglia, L.M.P. Plant Growth-Promoting Rhizobacteria (PGPR): Their Potential as Antagonists and Biocontrol Agents. Genet Mol. Biol. 2012, 35, 1044–1051. [Google Scholar] [CrossRef]
- Benizri, E.; Kidd, P.S. The role of the rhizosphere and microbes associated with hyperaccumulator plants in metal accumulation. In Agromining: Farming for Metals; Springer: Berlin/Heidelberg, Germany, 2018; pp. 157–188. [Google Scholar]
- Hossain, M.; Sultana, F.; Islam, S. Plant Growth-Promoting Fungi (PGPF): Phytostimulation and Induced Systemic Resistance. In Plant-Microbe Interactions in Agro-Ecological Perspectives; Springer: Singapore, 2017; pp. 135–191. ISBN 978-981-10-6592-7. [Google Scholar]
- Jahagirdar, S.; Kambrekar, D.N.; Navi, S.S.; Kunta, M. Plant Growth-Promoting Fungi: Diversity and Classification. In Bioactive Molecules in Plant Defense: Signaling in Growth and Stress; Jogaiah, S., Abdelrahman, M., Eds.; Springer International Publishing: Cham, Switzerland, 2019; pp. 25–34. ISBN 978-3-030-27165-7. [Google Scholar]
- Rosatto, S.; Roccotiello, E.; Di Piazza, S.; Cecchi, G.; Greco, G.; Zotti, M.; Vezzulli, L.; Mariotti, M. Rhizosphere Response to Nickel in a Facultative Hyperaccumulator. Chemosphere 2019. [Google Scholar] [CrossRef] [PubMed]
- Mishra, J.; Singh, R.; Arora, N.K. Alleviation of Heavy Metal Stress in Plants and Remediation of Soil by Rhizosphere Microorganisms. Front. Microbiol. 2017, 8, 1706. [Google Scholar] [CrossRef] [PubMed]
- Durand, A.; Piutti, S.; Rue, M.; Morel, J.L.; Echevarria, G.; Benizri, E. Improving Nickel Phytoextraction by Co-Cropping Hyperaccumulator Plants Inoculated by Plant Growth Promoting Rhizobacteria. Plant Soil 2016, 399, 179–192. [Google Scholar] [CrossRef]
- Goswami, D.; Thakker, J.N.; Dhandhukia, P.C. Simultaneous Detection and Quantification of Indole-3-Acetic Acid (IAA) and Indole-3-Butyric Acid (IBA) Produced by Rhizobacteria from l-Tryptophan (Trp) Using HPTLC. J. Microbiol. Methods 2015, 110, 7–14. [Google Scholar] [CrossRef] [PubMed]
- Khan, M.U.; Sessitsch, A.; Harris, M.; Fatima, K.; Imran, A.; Arslan, M.; Shabir, G.; Khan, Q.M.; Afzal, M. Cr-Resistant Rhizo- and Endophytic Bacteria Associated with Prosopis juliflora and Their Potential as Phytoremediation Enhancing Agents in Metal-Degraded Soils. Front. Plant Sci. 2015, 5. [Google Scholar] [CrossRef]
- Rue, M.; Vallance, J.; Echevarria, G.; Rey, P.; Benizri, E. Phytoextraction of Nickel and Rhizosphere Microbial Communities under Mono- or Multispecies Hyperaccumulator Plant Cover in a Serpentine Soil. Aust. J. Bot. 2015, 63, 92–102. [Google Scholar] [CrossRef]
- Kidd, P.S.; Álvarez-López, V.; Becerra-Castro, C.; Cabello-Conejo, M.; Prieto-Fernández, Á. Chapter Three-Potential Role of Plant-Associated Bacteria in Plant Metal Uptake and Implications in Phytotechnologies. In Advances in Botanical Research; Cuypers, A., Vangronsveld, J., Eds.; Phytoremediation; Academic Press: Cambridge, MA, USA, 2017; Volume 83, pp. 87–126. [Google Scholar]
- Thijs, S.; Langill, T.; Vangronsveld, J. Chapter Two-The Bacterial and Fungal Microbiota of Hyperaccumulator Plants: Small Organisms, Large Influence. In Advances in Botanical Research; Cuypers, A., Vangronsveld, J., Eds.; Phytoremediation; Academic Press: Cambridge, MA, USA, 2017; Volume 83, pp. 43–86. [Google Scholar]
- Effmert, U.; Kalderás, J.; Warnke, R.; Piechulla, B. Volatile Mediated Interactions between Bacteria and Fungi in the Soil. J. Chem. Ecol. 2012, 38, 665–703. [Google Scholar] [CrossRef] [PubMed]
- Han, H.L.; Chen, Z.; Yang, J.M.; Miao, C.C.; Zhang, K.; Jin, W.B.; Liu, Z. Field Scale Demonstration of Fungi-Bacteria Augmented Remediation of Petroleum-Contaminated Soil. Huan Jing Ke Xue/Huanjing Kexue 2008, 29, 454–461. [Google Scholar] [PubMed]
- Han, H.L.; Tang, J.; Jiang, H.; Zhang, M.L.; Liu, Z. Synergy between Fungi and Bacteria in Fungi-Bacteria Augmented Remediation of Petroleum-Contaminated Soil. Huan Jing Ke Xue/Huanjing Kexue 2008, 29, 189–195. [Google Scholar] [PubMed]
- Liu, S.-H.; Zeng, G.-M.; Niu, Q.-Y.; Liu, Y.; Zhou, L.; Jiang, L.-H.; Tan, X.; Xu, P.; Zhang, C.; Cheng, M. Bioremediation Mechanisms of Combined Pollution of PAHs and Heavy Metals by Bacteria and Fungi: A Mini Review. Bioresour. Technol. 2017, 224, 25–33. [Google Scholar] [CrossRef]
- Yuan, X.; Zhang, X.; Chen, X.; Kong, D.; Liu, X.; Shen, S. Synergistic Degradation of Crude Oil by Indigenous Bacterial Consortium and Exogenous Fungus Scedosporium boydii. Bioresour. Technol. 2018, 264, 190–197. [Google Scholar] [CrossRef]
- Agamennone, V.; Roelofs, D.; van Straalen, N.M.; Janssens, T.K.S. Antimicrobial Activity in Culturable Gut Microbial Communities of Springtails. J. Appl. Microbiol. 2018, 125, 740–752. [Google Scholar] [CrossRef]
- Trivedi, P.; Pandey, A.; Palni, L.M.S. In Vitro Evaluation of Antagonistic Properties of Pseudomonas corrugata. Microbiol. Res. 2008, 163, 329–336. [Google Scholar] [CrossRef] [PubMed]
- Roccotiello, E.; Serrano, H.C.; Mariotti, M.G.; Branquinho, C. Nickel Phytoremediation Potential of the Mediterranean Alyssoides utriculata (L.) Medik. Chemosphere 2015, 119, 1372–1378. [Google Scholar] [CrossRef] [PubMed]
- Cecchi, G.; Roccotiello, E.; Piazza, S.D.; Riggi, A.; Mariotti, M.G.; Zotti, M. Assessment of Ni Accumulation Capability by Fungi for a Possible Approach to Remove Metals from Soils and Waters. J. Environ. Sci. Health Part B 2017, 52, 166–170. [Google Scholar] [CrossRef] [PubMed]
- Hasani, A.; Kariminik, A.; Issazadeh, K. Streptomycetes: Characteristics and Their Antimicrobial Activities. Int. J. Adv. Biol. Biomed. Res. 2014, 2, 63–75. [Google Scholar]
- Sivasakthi, S.; Usharani, G.; Saranraj, P. Biocontrol Potentiality of Plant Growth Promoting Bacteria (PGPR)-Pseudomonas fluorescens and Bacillus subtilis: A Review. Afr. J. Agric. Res. 2014, 9, 1265–1277. [Google Scholar]
- van Ditmarsch, D.; Xavier, J.B. High-Resolution Time Series of Pseudomonas aeruginosa Gene Expression and Rhamnolipid Secretion through Growth Curve Synchronization. BMC Microbiol. 2011, 11, 140. [Google Scholar] [CrossRef] [PubMed]
- Hendricks, K.E.; Christman, M.C.; Roberts, P.D. A Statistical Evaluation of Methods of In-Vitro Growth Assessment for Phyllosticta citricarpa: Average Colony Diameter vs. Area. PLoS ONE 2017, 12. [Google Scholar] [CrossRef]
- Roccotiello, E.; Manfredi, A.; Drava, G.; Minganti, V.; Mariotti, M.G.; Berta, G.; Cornara, L. Zinc Tolerance and Accumulation in the Ferns Polypodium cambricum L. and Pteris vittata L. Ecotoxicol. Environ. Saf. 2010, 73, 1264–1271. [Google Scholar] [CrossRef]
- Marescotti, P.; Comodi, P.; Crispini, L.; Gigli, L.; Zucchini, A.; Fornasaro, S. Potentially Toxic Elements in Ultramafic Soils: A Study from Metamorphic Ophiolites of the Voltri Massif (Western Alps, Italy). Minerals 2019, 9, 502. [Google Scholar] [CrossRef]
- Abràmoff, M.D.; Magalhães, P.J.; Ram, S.J. Image Processing with ImageJ. Biophotonics Int. 2004, 11, 36–42. [Google Scholar]
- Rasband, W.S. 2011. ImageJ; US National Institutes of Health: Bethesda, MD, USA, 1997.
- Scales, B.S.; Dickson, R.P.; LiPuma, J.J.; Huffnagle, G.B. Microbiology, Genomics, and Clinical Significance of the Pseudomonas Fluorescens Species Complex, an Unappreciated Colonizer of Humans. Clin. Microbiol. Rev. 2014, 27, 927–948. [Google Scholar] [CrossRef] [PubMed]
- Manteca, Á.; Yagüe, P. Streptomyces Differentiation in Liquid Cultures as a Trigger of Secondary Metabolism. Antibiotics 2018, 7, 41. [Google Scholar] [CrossRef]
- Houbraken, J.; López-Quintero, C.A.; Frisvad, J.C.; Boekhout, T.; Theelen, B.; Franco-Molano, A.E.; Samson, R.A. Penicillium araracuarense sp. nov., Penicillium elleniae sp. nov., Penicillium penarojense sp. nov., Penicillium vanderhammenii sp. nov. and Penicillium wotroi sp. nov., Isolated from Leaf Litter. Int. J. Syst. Evol. Microbiol. 2011, 61, 1462–1475. [Google Scholar] [CrossRef]
- Hassan, M.; Gaber, A.; El-Hallous, E. Molecular and Morphological Characterization of Trichoderma harzianum from Different Egyptian Soils. Wulfenia J. 2014, 21, 80–96. [Google Scholar]
- Shah, S.; Nasreen, S.; Sheikh, P.A. Cultural and Morphological Characterization of Trichoderma spp. Associated with Green Mold Disease of Pleurotus spp. in Kashmirm. Res. J. Microbiol 2012, 7, 139–144. [Google Scholar] [CrossRef][Green Version]
- Savitha, M.J.; Sriram, S. Morphological and Molecular Identification of Trichoderma Isolates with Biocontrol Potential against Phytophthora Blight in Red Pepper. Pest Manag. Hortic. Ecosyst. 2015, 21, 194–202. [Google Scholar]
- Visagie, C.M.; Houbraken, J.; Frisvad, J.C.; Hong, S.-B.; Klaassen, C.H.W.; Perrone, G.; Seifert, K.A.; Varga, J.; Yaguchi, T.; Samson, R.A. Identification and Nomenclature of the Genus Penicillium. Stud. Mycol. 2014, 78, 343–371. [Google Scholar] [CrossRef]
- Wang, D.; Boukhalfa, H.; Ware, D.S.; Daligault, H.E. Draft Genome Sequence of a Chromium-Reducing Strain, Pseudomonas fluorescens S613, Isolated from a Chromium-Contaminated Aquifer in Los Alamos, New Mexico. Genome Announc. 2017, 5. [Google Scholar] [CrossRef] [PubMed]
- Wasi, S.; Tabrez, S.; Ahmad, M. Use of Pseudomonas spp. for the Bioremediation of Environmental Pollutants: A Review. Environ. Monit. Assess. 2013, 185, 8147–8155. [Google Scholar] [CrossRef]
- Tuthill, D.E.; Frisvad, J.C.; Christensen, M. Systematics of Penicillium simplicissimum Based on RDNA Sequences, Morphology and Secondary Metabolites. Mycologia 2001, 93, 298–308. [Google Scholar] [CrossRef]
- Domsch, K.H.; Gams, W.; Anderson, T.H. Compendium of Soil Fungi, 2nd ed.; Gams, W., Ed.; IHW: Eching, Germany, 2007. [Google Scholar]
- Bell, T.H.; Hassan, S.E.-D.; Lauron-Moreau, A.; Al-Otaibi, F.; Hijri, M.; Yergeau, E.; St-Arnaud, M. Linkage between Bacterial and Fungal Rhizosphere Communities in Hydrocarbon-Contaminated Soils Is Related to Plant Phylogeny. ISME J. 2014, 8, 331. [Google Scholar] [CrossRef] [PubMed]
- Jambon, I.; Thijs, S.; Weyens, N.; Vangronsveld, J. Harnessing Plant-Bacteria-Fungi Interactions to Improve Plant Growth and Degradation of Organic Pollutants. J. Plant Interact. 2018, 13, 119–130. [Google Scholar] [CrossRef]
- Hinsinger, P.; Gobran, G.R.; Gregory, P.J.; Wenzel, W.W. Rhizosphere Geometry and Heterogeneity Arising from Root-Mediated Physical and Chemical Processes. New Phytol. 2005, 168, 293–303. [Google Scholar] [CrossRef]
- Kuzyakov, Y. Factors Affecting Rhizosphere Priming Effects. J. Plant Nutr. Soil Sci. 2002, 165, 382–396. [Google Scholar] [CrossRef]
- Morgan, J.A.W.; Bending, G.D.; White, P.J. Biological Costs and Benefits to Plant–Microbe Interactions in the Rhizosphere. J. Exp. Bot 2005, 56, 1729–1739. [Google Scholar] [CrossRef]
- Rovira, A.D. Interactions Between Plant Roots and Soil Microorganisms. Annu. Rev. Microbiol. 1965, 19, 241–266. [Google Scholar] [CrossRef] [PubMed]
- Segura, A.; Rodríguez-Conde, S.; Ramos, C.; Ramos, J.L. Bacterial Responses and Interactions with Plants during Rhizoremediation. Microb. Biotechnol. 2009, 2, 452–464. [Google Scholar] [CrossRef] [PubMed]
Publisher’s Note: MDPI stays neutral with regard to jurisdictional claims in published maps and institutional affiliations. |
© 2021 by the authors. Licensee MDPI, Basel, Switzerland. This article is an open access article distributed under the terms and conditions of the Creative Commons Attribution (CC BY) license (http://creativecommons.org/licenses/by/4.0/).